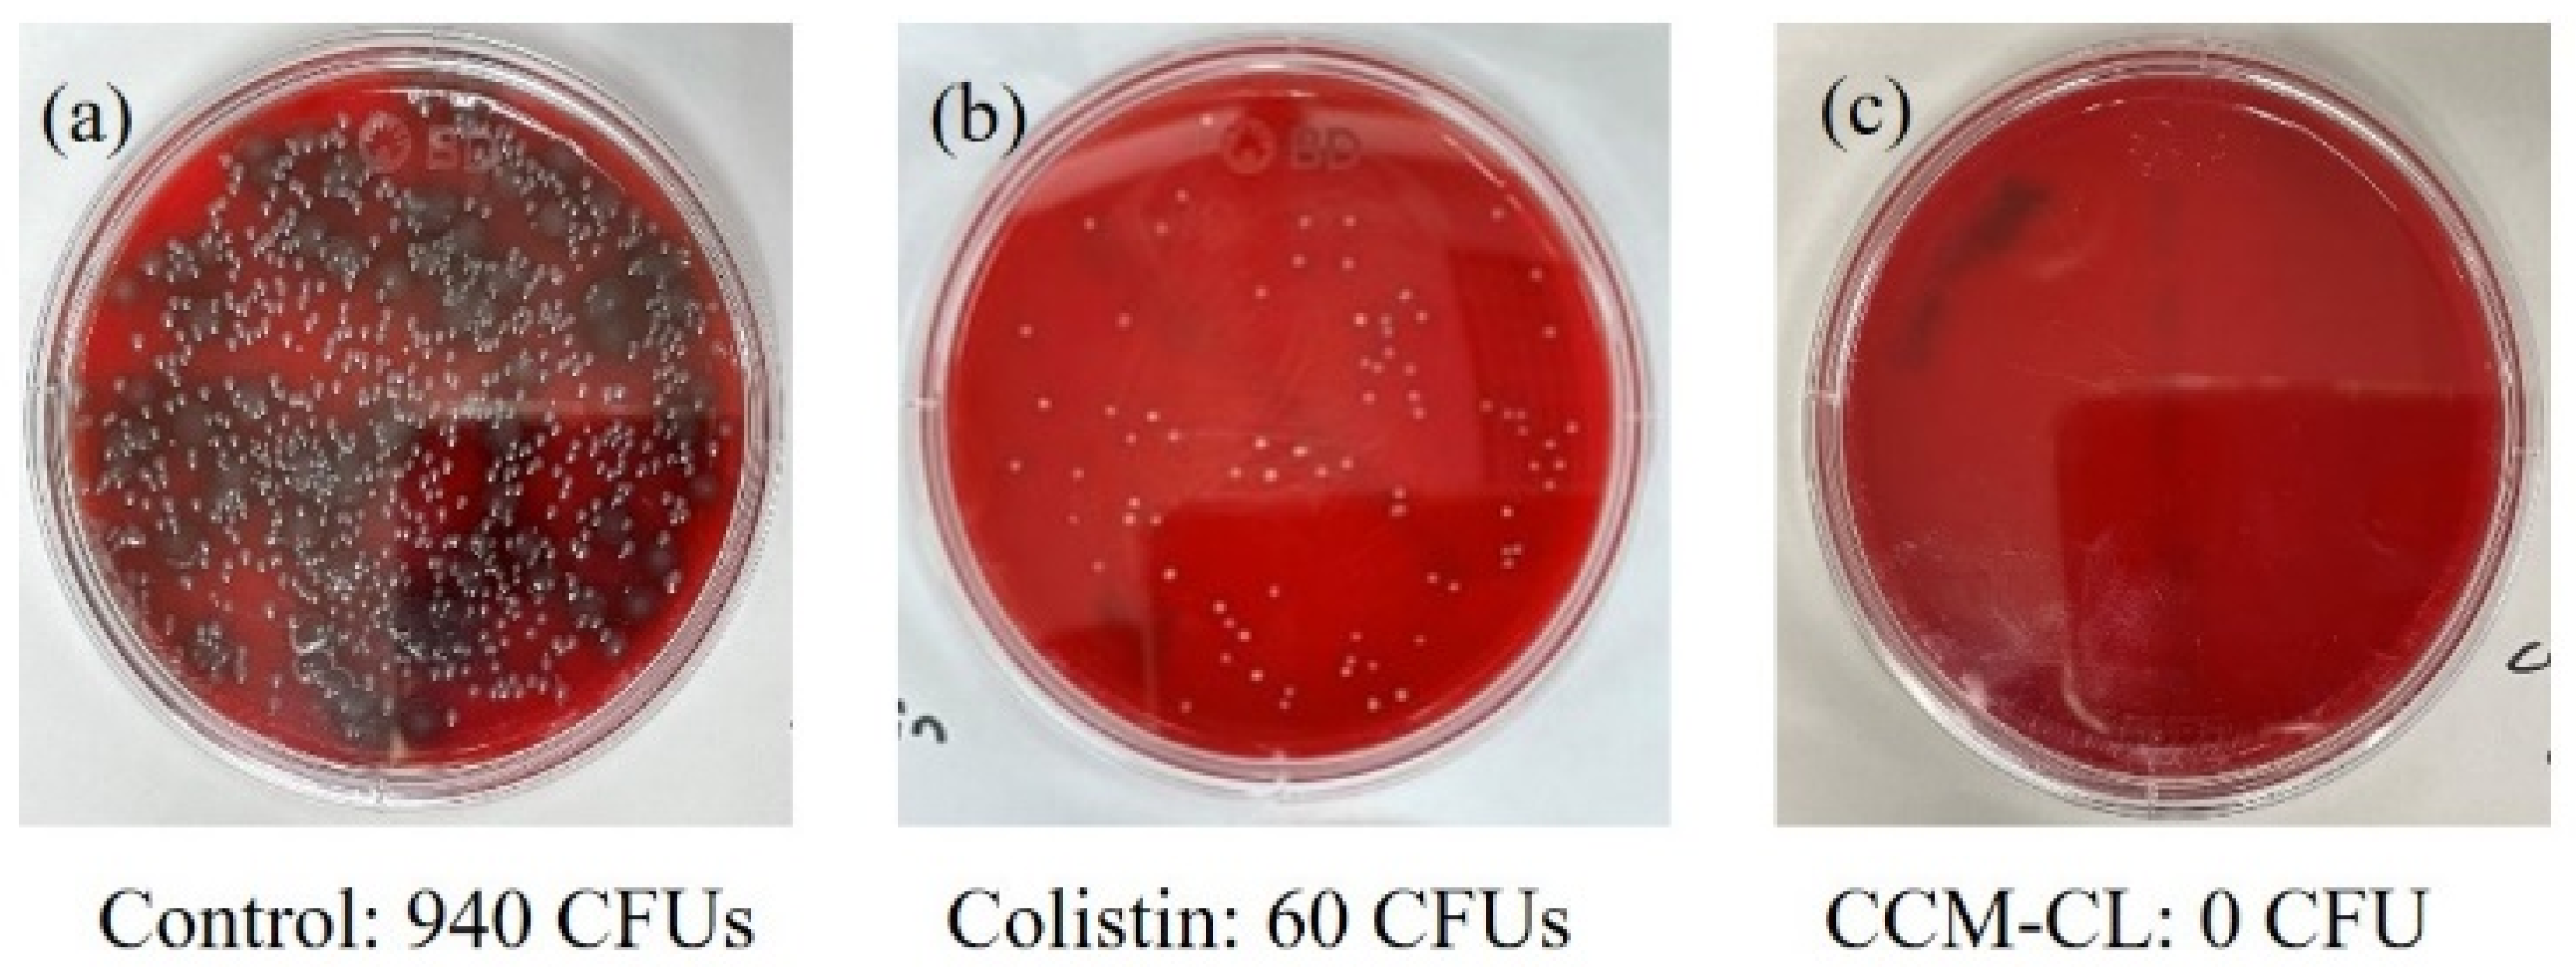

The Antimicrobial Effects of Colistin Encapsulated in Chelating Complex Micelles for the Treatment of Multi-Drug-Resistant Gram-Negative Bacteria: A Pharmacokinetic Study
Abstract
1. Introduction
2. Results
2.1. Characteristics of Colistin-Loaded Micelles
2.2. Analytical Method Validation for Pharmacokinetics Study
2.3. MICs of CCM-CL and Free Colistin for P. aeruginosa and A. baumannii
2.4. No Observed Adverse Effect Level (NOAEL)
2.5. Pharmacokinetic Study
2.6. Survival Study in the Murine Pneumonia Model
3. Discussion
4. Materials and Methods
4.1. Materials
4.2. Preparation of Colistin-Loaded CCM (CCM-CL)
4.3. Particle Size Characterization
4.4. Free Drug Content and Encapsulation Efficiency (EE%)
4.5. Liquid Chromatography Mass Spectrometry (LC-MS) Conditions for Pharmacokinetics Study
4.6. Analytical Method Validation for Pharmacokinetics Study
4.7. Antimicrobial Effects In Vitro
4.8. Animals
4.9. No Observed Adverse Effect Level (NOAEL)
4.10. Pharmacokinetics Study
4.11. Survival Curve
4.12. Bacterial Load in Lung
4.13. Statistical Analysis
Author Contributions
Funding
Institutional Review Board Statement
Informed Consent Statement
Data Availability Statement
Acknowledgments
Conflicts of Interest
References
- Magiorakos, A.P.; Srinivasan, A.; Carey, R.B.; Carmeli, Y.; Falagas, M.E.; Giske, C.G.; Harbarth, S.; Hindler, J.F.; Kahlmeter, G.; Olsson-Liljequist, B.; et al. Multidrug-resistant, extensively drug-resistant and pandrug-resistant bacteria: An international expert proposal for interim standard definitions for acquired resistance. Clin. Microbiol. Infect. 2012, 18, 268–281. [Google Scholar] [CrossRef] [PubMed]
- Bassetti, M.; Poulakou, G.; Ruppe, E.; Bouza, E.; Van Hal, S.J.; Brink, A. Antimicrobial resistance in the next 30 years, humankind, bugs and drugs: A visionary approach. Intensive Care Med. 2017, 43, 1464–1475. [Google Scholar] [CrossRef] [PubMed]
- CDC. Antibiotic Resistance Threats in the United States, 2019; Centers for Disease Control and Prevention: Atlanta, GA, USA, 2019.
- Nation, R.L.; Li, J.; Cars, O.; Couet, W.; Dudley, M.N.; Kaye, K.S.; Mouton, J.W.; Paterson, D.L.; Tam, V.H.; Theuretzbacher, U.; et al. Framework for optimisation of the clinical use of colistin and polymyxin B: The Prato polymyxin consensus. Lancet Infect. Dis. 2015, 15, 225–234. [Google Scholar] [CrossRef] [PubMed]
- Li, J.; Nation, R.L.; Turnidge, J.D.; Milne, R.W.; Coulthard, K.; Rayner, C.R.; Paterson, D.L. Colistin: The re-emerging antibiotic for multidrug-resistant Gram-negative bacterial infections. Lancet Infect. Dis. 2006, 6, 589–601. [Google Scholar] [CrossRef] [PubMed]
- Velkov, T.; Thompson, P.E.; Nation, R.L.; Li, J. Structure--activity relationships of polymyxin antibiotics. J. Med. Chem. 2010, 53, 1898–1916. [Google Scholar] [CrossRef]
- Koch-Weser, J.; Sidel, V.W.; Federman, E.B.; Kanarek, P.; Finer, D.C.; Eaton, A.E. Adverse effects of sodium colistimethate. Manifestations and specific reaction rates during 317 courses of therapy. Ann. Intern. Med. 1970, 72, 857–868. [Google Scholar] [CrossRef]
- Couet, W.; Grégoire, N.; Marchand, S.; Mimoz, O. Colistin pharmacokinetics: The fog is lifting. Clin. Microbiol. Infect. 2012, 18, 30–39. [Google Scholar] [CrossRef]
- Nation, R.L.; Li, J. Colistin in the 21st century. Curr. Opin. Infect. Dis. 2009, 22, 535–543. [Google Scholar] [CrossRef]
- Tran, T.B.; Velkov, T.; Nation, R.L.; Forrest, A.; Tsuji, B.T.; Bergen, P.J.; Li, J. Pharmacokinetics/pharmacodynamics of colistin and polymyxin B: Are we there yet? Int. J. Antimicrob. Agents 2016, 48, 592–597. [Google Scholar] [CrossRef]
- Spapen, H.; Jacobs, R.; Van Gorp, V.; Troubleyn, J.; Honoré, P.M. Renal and neurological side effects of colistin in critically ill patients. Ann. Intensive Care 2011, 1, 14. [Google Scholar] [CrossRef]
- Walvekar, P.; Gannimani, R.; Govender, T. Combination drug therapy via nanocarriers against infectious diseases. Eur. J. Pharm. Sci. 2019, 127, 121–141. [Google Scholar] [CrossRef]
- Abdelghany, S.M.; Quinn, D.J.; Ingram, R.J.; Gilmore, B.F.; Donnelly, R.F.; Taggart, C.C.; Scott, C.J. Gentamicin-loaded nanoparticles show improved antimicrobial effects towards Pseudomonas aeruginosa infection. Int. J. Nanomed. 2012, 7, 4053–4063. [Google Scholar] [CrossRef]
- Sabaeifard, P.; Abdi-Ali, A.; Gamazo, C.; Irache, J.; Soudi, M. Improved effect of amikacin-loaded poly(D,L-lactide-co-glycolide) nanoparticles against planktonic and biofilm cells of Pseudomonas aeruginosa. J. Med. Microbiol. 2017, 66, 137–148. [Google Scholar] [CrossRef]
- Bertrand, N.; Grenier, P.; Mahmoudi, M.; Lima, E.M.; Appel, E.A.; Dormont, F.; Lim, J.-M.; Karnik, R.; Langer, R.; Farokhzad, O.C. Mechanistic understanding of in vivo protein corona formation on polymeric nanoparticles and impact on pharmacokinetics. Nat. Commun. 2017, 8, 777. [Google Scholar] [CrossRef]
- Azzopardi, E.A.; Ferguson, E.L.; Thomas, D.W. The enhanced permeability retention effect: A new paradigm for drug targeting in infection. J. Antimicrob. Chemother. 2013, 68, 257–274. [Google Scholar] [CrossRef]
- Maeda, H.; Wu, J.; Sawa, T.; Matsumura, Y.; Hori, K. Tumor vascular permeability and the EPR effect in macromolecular therapeutics: A review. J. Control. Release 2000, 65, 271–284. [Google Scholar] [CrossRef]
- Greenwald, R.B. PEG drugs: An overview. J. Control. Release 2001, 74, 159–171. [Google Scholar] [CrossRef]
- Alconcel, S.N.S.; Baas, A.S.; Maynard, H.D. FDA-approved poly(ethylene glycol)–protein conjugate drugs. Polym. Chem. 2011, 2, 1442–1448. [Google Scholar] [CrossRef]
- Chen, C.H.; Kuo, M.L.; Wang, J.L.; Liao, W.C.; Chang, L.C.; Chan, L.P.; Lin, J. CCM-AMI, a Polyethylene Glycol Micelle with Amifostine, as an Acute Radiation Syndrome Protectant in C57BL/6 Mice. Health Phys. 2015, 109, 242–248. [Google Scholar] [CrossRef]
- Wang, C.H.; Cheng, C.Y.; Chen, C.H.; Liao, W.C.; Lin, J. Chelating Complex Micelles for Delivering Cytoprotectant Amifostine and its Application in Radiation Protection. J. Pharmacovigil. 2018, 6, 1000263. [Google Scholar]
- Wang, C.H.; Chen, C.H.; Lin, J.; Chen, J.Y.; Liao, W.C. Drug Carrier with Chelating Complex Micelles and the Application Thereof. U.S. Patent 8785569B2, 22 July 2014. [Google Scholar]
- Bergen, P.J.; Li, J.; Nation, R.L. Dosing of colistin-back to basic PK/PD. Curr. Opin. Pharmacol. 2011, 11, 464–469. [Google Scholar] [CrossRef] [PubMed]
- Stites, S.W.; Nelson, M.E.; Wesselius, L.J. Transferrin concentrations in serum and lower respiratory tract fluid of mechanically ventilated patients with COPD or ARDS. Chest 1995, 107, 1681–1685. [Google Scholar] [CrossRef] [PubMed]
- Lim, L.M.; Ly, N.; Anderson, D.; Yang, J.C.; Macander, L.; Jarkowski, A.; Forrest, A.; Bulitta, J.B.; Tsuji, B.T. Resurgence of colistin: A review of resistance, toxicity, pharmacodynamics, and dosing. Pharmacotherapy 2010, 30, 1279–1291. [Google Scholar] [CrossRef] [PubMed]
- Ogunleye, A.; Bhat, A.; Irorere, V.U.; Hill, D.; Williams, C.; Radecka, I. Poly-gamma-glutamic acid: Production, properties and applications. Microbiology 2015, 161, 1–17. [Google Scholar] [CrossRef]
- Ashiuchi, M.; Kamei, T.; Baek, D.H.; Shin, S.Y.; Sung, M.H.; Soda, K.; Yagi, T.; Misono, H. Isolation of Bacillus subtilis (chungkookjang), a poly-gamma-glutamate producer with high genetic competence. Appl. Microbiol. Biotechnol. 2001, 57, 764–769. [Google Scholar] [CrossRef]
- Ahn, H.; Kang, S.G.; Yoon, S.I.; Kim, P.H.; Kim, D.; Lee, G.S. Poly-gamma-glutamic acid from Bacillus subtilis upregulates pro-inflammatory cytokines while inhibiting NLRP3, NLRC4 and AIM2 inflammasome activation. Cell. Mol. Immunol. 2018, 15, 111–119. [Google Scholar] [CrossRef]
- Ackland, G.L.; Gutierrez, D.A.A.; Yao, S.T.; Stephens, R.C.; Dyson, A.; Klein, N.J.; Singer, M.; Gourine, A.V. Low-molecular-weight polyethylene glycol improves survival in experimental sepsis. Crit. Care Med. 2010, 38, 629–636. [Google Scholar] [CrossRef]
- CLSI. Performance Standards for Antimicrobial Susceptibility Testing, 30th ed.; CLSI supplement M100; CLSI: Wayne, PA, USA, 2020. [Google Scholar]
- Garonzik, S.M.; Li, J.; Thamlikitkul, V.; Paterson, D.L.; Shoham, S.; Jacob, J.; Silveira, F.P.; Forrest, A.; Nation, R.L. Population Pharmacokinetics of Colistin Methanesulfonate and Formed Colistin in Critically Ill Patients from a Multicenter Study Provide Dosing Suggestions for Various Categories of Patients. Antimicrob. Agents Chemother. 2011, 55, 3284–3294. [Google Scholar] [CrossRef]
- Moni, M.; Sudhir, A.S.; Dipu, T.S.; Mohamed, Z.; Prabhu, B.P.; Edathadathil, F.; Balachandran, S.; Singh, S.K.; Prasanna, P.; Menon, V.P.; et al. Clinical efficacy and pharmacokinetics of colistimethate sodium and colistin in critically ill patients in an Indian hospital with high endemic rates of multidrug-resistant Gram-negative bacterial infections: A prospective observational study. Int. J. Infect. Dis. 2020, 100, 497–506. [Google Scholar] [CrossRef]
- Bergen, P.J.; Li, J.; Rayner, C.R.; Nation, R.L. Colistin methanesulfonate is an inactive prodrug of colistin against Pseudomonas aeruginosa. Antimicrob. Agents Chemother. 2006, 50, 1953–1958. [Google Scholar] [CrossRef]
- Fleming, R.E.; Ponka, P. Iron Overload in Human Disease. N Engl. J. Med. 2012, 366, 348–359. [Google Scholar] [CrossRef]
- Zhang, Y.; Huo, M.; Zhou, J.; Xie, S. PKSolver: An add-in program for pharmacokinetic and pharmacodynamic data analysis in Microsoft Excel. Comput. Methods Programs Biomed. 2010, 99, 306–314. [Google Scholar] [CrossRef]

| Colistin | CCM-CL | |
|---|---|---|
| Pseudomonas aeruginosa ATCC27853 | 0.5 | 0.5 |
| Pseudomonas aeruginosa 048431 | 0.5 | 0.5 |
| Acinetobacter baumannii 10591 | 2 | 2 |
| Administration Mode | Samples | Concentration (mg/mL) | Dose (mg/kg) | No. of Survival/Total Mice |
|---|---|---|---|---|
| Bolus injection | Control | 0 | 0 | 5/5 |
| Colistin | 6 | 20 | 1/3 | |
| 13 | 0/1 | |||
| 8 | 5/5 | |||
| CCM-CL | 6 | 20 | 2/3 | |
| 13 | 6/6 | |||
| Slow infusion | Colistin | 6 | 13 | 0/1 |
| CCM-CL | 6 | 20 | 0/1 | |
| 16 | 2/2 |
| Group | t1/2 | Tmax | Cmax | AUC0–t | AUC0–inf |
|---|---|---|---|---|---|
| (min) | (mg/L) | (mg/L) | (mg/L × min) | (mg/L × min) | |
| Colistin | 12.46 | 15 | 9.03 | 239.31 | 239.32 |
| CCM-CL | 9.61 (α) 102.23 (β) | 15 | 24.19 | 976.33 | 1185.64 |
Disclaimer/Publisher’s Note: The statements, opinions and data contained in all publications are solely those of the individual author(s) and contributor(s) and not of MDPI and/or the editor(s). MDPI and/or the editor(s) disclaim responsibility for any injury to people or property resulting from any ideas, methods, instructions or products referred to in the content. |
© 2023 by the authors. Licensee MDPI, Basel, Switzerland. This article is an open access article distributed under the terms and conditions of the Creative Commons Attribution (CC BY) license (https://creativecommons.org/licenses/by/4.0/).
Share and Cite
Liao, W.-C.; Wang, C.-H.; Sun, T.-H.; Su, Y.-C.; Chen, C.-H.; Chang, W.-T.; Chen, P.-L.; Shiue, Y.-L. The Antimicrobial Effects of Colistin Encapsulated in Chelating Complex Micelles for the Treatment of Multi-Drug-Resistant Gram-Negative Bacteria: A Pharmacokinetic Study. Antibiotics 2023, 12, 836. https://doi.org/10.3390/antibiotics12050836
Liao W-C, Wang C-H, Sun T-H, Su Y-C, Chen C-H, Chang W-T, Chen P-L, Shiue Y-L. The Antimicrobial Effects of Colistin Encapsulated in Chelating Complex Micelles for the Treatment of Multi-Drug-Resistant Gram-Negative Bacteria: A Pharmacokinetic Study. Antibiotics. 2023; 12(5):836. https://doi.org/10.3390/antibiotics12050836
Chicago/Turabian StyleLiao, Wei-Chuan, Chau-Hui Wang, Tzu-Hui Sun, Yu-Cheng Su, Chia-Hung Chen, Wen-Teng Chang, Po-Lin Chen, and Yow-Ling Shiue. 2023. "The Antimicrobial Effects of Colistin Encapsulated in Chelating Complex Micelles for the Treatment of Multi-Drug-Resistant Gram-Negative Bacteria: A Pharmacokinetic Study" Antibiotics 12, no. 5: 836. https://doi.org/10.3390/antibiotics12050836
APA StyleLiao, W.-C., Wang, C.-H., Sun, T.-H., Su, Y.-C., Chen, C.-H., Chang, W.-T., Chen, P.-L., & Shiue, Y.-L. (2023). The Antimicrobial Effects of Colistin Encapsulated in Chelating Complex Micelles for the Treatment of Multi-Drug-Resistant Gram-Negative Bacteria: A Pharmacokinetic Study. Antibiotics, 12(5), 836. https://doi.org/10.3390/antibiotics12050836

